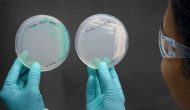

最近新冠病毒席卷全球,絕大多數(shù)國家都采取了中國模式、即盡最大可能減少民眾接觸機(jī)會。但英國截止昨天卻沒有任何限制措施,政府發(fā)布的應(yīng)對策略表達(dá)不清、引起嚴(yán)重誤解和抗議。
Continue reading …
今天武田和Alnylam宣布加入抗新冠病毒行動。武田將開發(fā)康復(fù)新冠患者血漿中提取的多克隆超免疫球蛋白(H-IG,代號TAK-888),希望能用來中和重癥患者的病毒。武田2009年H1N1大流行時曾收集15,000升患者血漿、
Continue reading …
新冠造成全球大流行的風(fēng)險(xiǎn)與日俱增,甚至可能成為象流感一樣的季節(jié)性流行疾病。今天就講一講對抗這個病毒的幾個核心挑戰(zhàn)和策略。
Continue reading …
今天恒大集團(tuán)宣布將出資1.15億美元資助廣州呼吸健康研究院與美國哈佛大學(xué)醫(yī)學(xué)院共同研究新冠病毒的診斷、疫苗、抗病毒藥物、以及新冠毒理學(xué)。中方領(lǐng)軍人物為鐘南山院士、美方負(fù)責(zé)人為George Daley教授,合作期限為5年。
Continue reading …
最近《細(xì)胞》雜志發(fā)表了一篇MIT、哈佛、Broad、McMaster科學(xué)家合作通過人工智能發(fā)現(xiàn)廣譜抗菌素的文章。作者先在自己的抗菌實(shí)驗(yàn)中篩選了1700個FDA批準(zhǔn)藥物和800個活性天然產(chǎn)物,
Continue reading …
COVID雖然已經(jīng)被包圍、但對全球的威脅依然存在,這也引起了跨國制藥集團(tuán)的注意。今天強(qiáng)生旗下楊森制藥繼上周宣布將開發(fā)COVID疫苗后今天宣布將開始篩選他們的小分子抗病毒藥物庫
Continue reading …
2月16日,國家藥監(jiān)局批準(zhǔn)了海正藥業(yè)的仿制藥法匹拉韋用于其它抗流感病毒藥物治療無效或效果不佳時成人新型或復(fù)發(fā)流感的治療。法匹拉韋(英文名favipiravir
Continue reading …
據(jù)不完全統(tǒng)計(jì)自1月23日武漢封城以來中國已經(jīng)啟動了近120個針對COVID19新冠病毒的中西藥臨床試驗(yàn)。雖然今天科技部生物中心宣布抗瘧老藥氯喹在一系列臨床指標(biāo)如重癥化率、肺部影像等顯著優(yōu)于對照組,因此將被列入新版新冠肺炎治療方案
Continue reading …
這次疫情仍然沒有得到顯著緩解。雖然采取了嚴(yán)格隔離措施和最大化醫(yī)療援助,但新冠病毒依然肆虐。無論科研人員還是普通百姓都希望盡快找到能夠控制新冠的有效藥物,一個最快的辦法就是老藥新用、即把已經(jīng)上市或有人體數(shù)據(jù)的其它疾病藥物借來用于治療新冠。最近幾天看最有前景的藥物是吉利德科學(xué)為埃博拉病毒開發(fā)的廣譜抗病毒藥物瑞得西韋,一時間廟堂依之為長城、草野望之如時雨。那么這個藥成功的可能性有多
Continue reading …
昨天世界衛(wèi)生組織宣布新冠病毒為全球關(guān)注突發(fā)公共衛(wèi)生事件,今天美國疾病控制中心宣布從中國回到美國的195位公民隔離14天,新英格蘭醫(yī)學(xué)雜志則正式報(bào)道了第一例無癥狀病毒傳播者。
Continue reading …
今天美國衛(wèi)生部向法庭提出訴訟指控吉利德科學(xué)使用其艾滋病藥物Truvada和Descovy用于感染前預(yù)防(PrEP)侵犯了CDC在2015年獲得的一項(xiàng)用途專利
Continue reading …
鹽野義制藥株式會社今天宣布其頭孢菌素-鐵載體偶聯(lián)藥物cefiderocol在一個革蘭氏陰性菌引起的院內(nèi)感染肺炎三期臨床達(dá)到試驗(yàn)終點(diǎn)。
Continue reading …
今天美國mRNA技術(shù)公司Moderna公布了兩個mRNA產(chǎn)品的一期臨床數(shù)據(jù)。一個產(chǎn)品是巨細(xì)胞病毒(CMV)疫苗mRNA-1647。這個產(chǎn)品共有6段mRNA,其中五條編碼膜上的5個亞單位、第六條編碼糖蛋白B。
Continue reading …
今天FDA通過優(yōu)先審批通道批準(zhǔn)了默沙東的抗生素組合Recarbrio用于復(fù)雜尿路感染(cUTI)和腹腔感染(cIAI)。 Recarbrio是三個藥物組合,其中只有亞胺培南是抗生素。其它兩個組分西司他丁、relebactam分別為人體腎二肽酶和細(xì)菌beta-內(nèi)酰胺酶抑制劑,作用是延長亞胺培南的半衰期。亞胺培南、西司他丁組合已經(jīng)是上市藥物(商品名Primaxin)。
Continue reading …
最近J. Med. Chem. 發(fā)表一篇范德堡大學(xué)科學(xué)家的綜述文章,介紹當(dāng)前天然產(chǎn)物改造的技術(shù)進(jìn)展。這篇題為“Fixing the Unfixable: The Art of Optimizing Natural Products for Human Medicine”以pactamycin、多烯大環(huán)內(nèi)酯、四環(huán)素等活性天然產(chǎn)物為例綜述了
Continue reading …
最近一種對多種藥物耐藥真菌在美國及世界各地的蔓延引起業(yè)界和公眾關(guān)注。這個叫做C.auris的真菌最早于2009年在日本發(fā)現(xiàn),自2013年進(jìn)入美國以來已經(jīng)有近600例確認(rèn)感染,主要發(fā)生在紐約、芝加哥等大城市及周邊的醫(yī)院。雖然感染者多為免疫能力低下的重癥患者,但30-60%的死亡率還是引起CDC的高度關(guān)注。這種真菌對氟康唑普遍耐藥,對其它真菌藥物也有不同程度耐藥,所以威脅較大。C.auris傳染性較強(qiáng)、而且不容易診斷,也成為一個危險(xiǎn)因素。
Continue reading …
上周《科學(xué)轉(zhuǎn)化醫(yī)學(xué)》雜志發(fā)表一篇奎寧作用機(jī)理的文章。這個工作利用質(zhì)譜加細(xì)胞內(nèi)熱遷移(MS-CETSA)技術(shù)分析奎寧和甲氟喹
Continue reading …




















 微信號:美中藥源
微信號:美中藥源